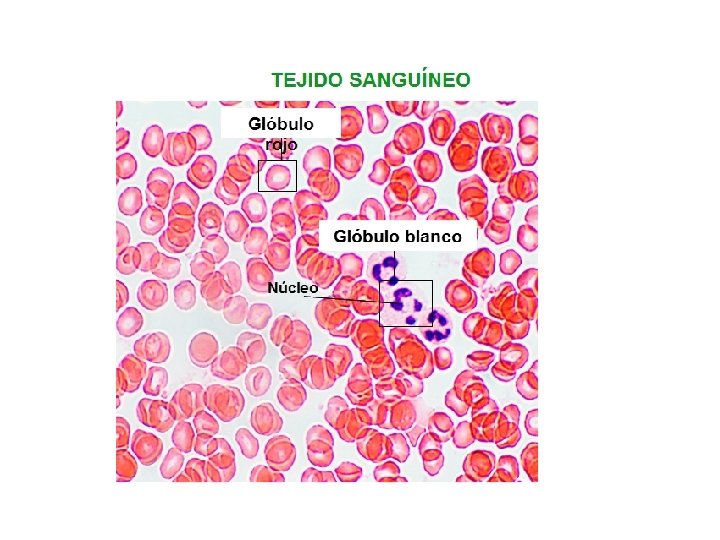

La clula y el ser humano La clula

- Slides: 36
La célula y el ser humano
La célula: • Es la unidad estructural de los seres vivos (todos formados por células) • Es la unidad funcional (realiza todos los procesos que le permiten vivir) • Es la unidad de reproducción (procede de otra ya existente) • Es la unidad genética (contienen el material hereditario que pasa de células madres a hijas)
Membrana celular Citoplasma Agua y sustancias disueltas Orgánulos Núcleo Contiene el ADN o material genético Regula el intercambio de sustancias
Forma y tamaños celulares El tamaño de las células oscila dentro amplios limites. Si bien algunas células pueden observarse a simple vista la mayoría de ellas son visibles únicamente al microscopio. En los tipos comunes de células se puede a preciar un rango de tamaño que oscila entre 1 o 100 micrómetros. Las células gigantes como las del alga Acetabularia ( 2 a 3 centímetros) y el huevo del avestruz ( 8 o 10 centímetros), representan casos excepcionales
CÉLULAS EUCARIOTAS • En una célula eucariota podemos distinguir las tres partes fundamentales: membrana, citoplasma y núcleo. • Membrana: Capa continua que envuelve la célula y le confiere su individualidad. • Citoplasma: Esta formado por un medio acuoso, el citosol, y los orgánulos. • Núcleo: el orgánulo más voluminoso de la célula y donde se contiene la mayor parte del ADN celular. • Forman parte de todos los animales y vegetales pluricelulares y también de una gran variedad de microorganismos: protozoos, algas y hongos.
La estructura de las células humanas Membrana plasmática Centrosomas Mitocondria Citoplasma Aparato de Golgi Núcleo Retículo endoplasmático Vacuolas Ribosomas Lisosomas
Características de las células humanas Óvulo. Redondeado Ø 100 - 200 μm Espermatozoide. Con flagelo Ø cabeza 3 μm Glóbulo rojo. Bicóncavo Ø 8 μm Célula muscular. Fusiforme Ø 10 μm Célula epitelial. Aplanada Ø 0, 2 - 15 μm Leucocito. Esférico Ø 12 - 15 μm Neurona. Estrellada. Hasta varios centímetros Célula conectiva. Redondeada Ø 0, 5 - 20 μm
Membrana plasmática Vista al microscopio electrónico Membrana plasmática: – Es una fina lámina que rodea a la célula y la protege. – Compuesta por: • Una doble capa de lípidos • Proteínas entre los lípidos • Glúcidos en la cara externa de la membrana – Permite y regula el paso de sustancias hacia el interior y el exterior de la célula. Estructura de la membrana plasmática Proteína Lípidos
El núcleo celular En él se encuentra la mayoría del ADN celular, con la información genética. Las células suelen tener un solo núcleo, a excepción de las polinucleadas (en las células musculares estriadas), o carecer de él (los glóbulos rojos). 2 y 4 1. Envoltura nuclear Con doble membrana, la externa conectada con el Retículo Endoplasmático. Las membranas con poros que se comunican con el citoplasma. 2. Nucleoplasma Medio acuoso del interior. 3. Nucléolo. Corpúsculo esférico sin membrana. Su función es la formación de los ribosomas. Puede haber más de uno en la célula. 4. Cromatina. Filamentos de ADN asociados a proteínas. Cuando la célula se va a dividir, se organizan y condensan en cromosomas. 3 1
Diferenciación celular • Durante el desarrollo embrionario a medida que las células se reproducen sufren un proceso de especialización que dará lugar a los diferentes tipos de células y tejidos. • La diferenciación celular es el proceso por el cual las células se especializan. • Esa especialización conlleva cambios en: – La forma celular: Hay formas esféricas, prismáticas, alargadas, estrelladas, etc – La función: contracción muscular, impulso nervioso, almacenar sustancias, transportar oxígeno, etc – Actividad de orgánulos citoplasmáticos: Dependiendo de la función unas células tendrán mayor numero de orgánulos que otras. Ej: Las células musculares poseen numerosas mitocondrias por su necesidad de energía.
En un ser pluricelular como nosotros: 1. Todas las células provienen de una llamada célula huevo o cigoto 2. Las células se especializan para realizar funciones concretas 3. El trabajo se reparte entre todas las células 4. El trabajo está coordinado CELULA TEJIDO : Asociación de células identicas. ÓRGANO : Asociación de tejidos que realizan una función común SISTEMAS O APARATOS: Asociación de órganos con una función general ORGANISMO
Tú comenzaste siendo una célula, luego dos, luego cuatro… 2 células 4 células 8 células ¿Cuántas células crees que tienes ahora?
¡ 50. 000 millones! ¡Es el número de células que tiene tu organismo! Células Músculo Células Capa grasa del abdomen Glóbulos blancos Glóbulos rojos Esófago Cartílago Células de la sangre Hueso
Las células se agrupan en tejidos. Las células de un mismo tejido son muy similares entre sí. Hay cuatro tipos básicos de tejido: tejido epitelial tejido muscular tejido nervioso tejido conectivo que puede ser conjuntivo cartilaginoso adiposo óseo sanguíneo
TEJIDO EPITELIAL El tejido epitelial o epitelio está formado por una o varias capas de células, que se disponen unas al lado de otras sin dejar espacios entre ellas. Este tejido recubre la superficie externa del cuerpo, y forma la piel, y el interior de los conductos y órganos huecos, como el estómago. Epitelio de revestimiento Epitelio glandular Glándula sebácea Epidermis Glándulas exocrinas Mucosas Endotelios Páncreas Glándulas mixtas Hipófisis Glándulas endocrinas
TEJIDO MUSCULAR El tejido muscular está formado por células con forma alargada, las fibras musculares. Estas fibras son contráctiles, es decir, ante un estímulo pueden acortarse. El tejido muscular forma los músculos del aparato locomotor (músculos esqueléticos), del corazón (músculo cardíaco o miocardio) y de las paredes de distintos órganos (músculo liso).
Tejido muscular estriado Numerosos núcleos Músculo esquelético Bíceps Tejido muscular liso Tejido muscular cardíaco Un solo núcleo Vasos sanguíneos Un solo núcleo Corazón
TEJIDO NERVIOSO El tejido nervioso está formado por las neuronas, células capaces de captar y de responder a los estímulos, y de controlar la actividad del organismo.
TEJIDO CONECTIVO El tejido conectivo está formado por células separadas por una sustancia intercelular denominada matriz. Sirve de unión y soporte. • Tejido conjuntivo. Está entre otros tejidos y entre los órganos uniéndolos. Ej. : tendones y ligamentos. • Tejido cartilaginoso. Forma los cartílagos que sirven de sostén a algunas estructuras del cuerpo y para proteger del rozamiento los extremos de los huesos. Ej. : el cartílago de la rodilla, la tráquea, la nariz, el pabellón de la oreja, etc. • Tejido adiposo. Es el tejido graso. Sus células se llaman adipocitos y se encuentran llenas de grasa. Su función es servir de reserva, de protección de algunos órganos y de aislante térmico. • Tejido óseo. Compuesto por células llamadas osteocitos de forman una sustancia intercelular sólida, compuesta por sales minerales. Constituye los huesos. • Tejido sanguíneo. Formado por las células que forman la sangre, . La sustancia intercelular es el plasma sanguíneo. Sirve de defensa (glóbulos blancos), para transportar el oxígeno a las células (glóbulos rojos), etc.
La unión de varios tejidos constituye un Órgano, que desempeña una función concreta en un Aparato o Sistema. Tejidos del corazón Tejido muscular Tejido epitelial de revestimiento Tejido conjuntivo Tejido adiposo
Ejemplos de órganos: Corazón Forma parte del Hueso Forma parte del Aparato Circulatorio Cerebro Forma parte del Sistema Óseo Sistema Nervioso
• Los órganos que trabajan en conjunto forman un aparato o sistema de órganos.
Las células musculares (fibras musculares) que forman las células óseas que formen el tejido muscular el tejido oseo que forma órganos (músculos) que forman el sistema muscular que forman el sistema esquelético órganos (huesos)
Aparatos y sistemas para realizar la función de nutrición el digestivo el respiratorio el circulatorio el linfático el excretor
Sistemas para realizar la función de relación el nervioso el endocrino el muscular el esquelético
Aparatos para realizar la función de reproducción el reproductor femenino el reproductor masculino
Las células se agrupan en tejidos, los tejidos forman órganos y los órganos forman aparatos o sistemas, que forman en conjunto al organismo.